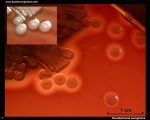

دكتر رضا میرنژاد ( باكتریولوژیست)
Nonfermentative gram negative bacilli and cocobacilli (NFB)
این باسیلها در خاک، آب و سطوح مخاطی انسان و حیوانات وجود دارند. در افرادی که ضعف سیستم ایمنی وجود دارد و یا در صورت دسترسی باکتری به محلهای استریل بدن، بیماریزا میباشند. در نمونههای کلینیکی کمتر از 20% باسیلهای گرم منفی که با آنها مواجه میشویم از نوع NFB هستند که حدود 70% آنها سودوموناس آئروژینوزا پیوسینانوژنیک میباشند. بقیه به ترتیب فراوانی عبارتند از: اسینتوباکتر، استنوترفوموناس مالتوفیلا، بورخولدریا سپاشیا، بورخولدریا سودومالئی، بورخولدریا مالئی، آلکالیژنها، اکتینوباسیلوسها و غیره.
ابزارهای اصلی تشخیص NFB بررسی تخمیر قندها در محیط OF، تست اکسیداز، بررسی وضعیت فلاژل و غیره میباشد. این باکتریها اکثرا” به پلیمیکسین حساس هستند.
محیط ( Hugh- Leifson ) O-F
این محیط حاوی 0/2 درصد پپتون و یك درصد قند (در انتروباكتریاسه به نسبت 2/1) بوده که كاهش پپتون جهت تشكیل محصولات اكسیداسیون از اسیدهای آمینه در نتیجه افزایش PH لازم میباشد. کشت باکتری برروی این محیط به شکل خطی و عمقی در دو لوله حاوی محیط کشت انجام میگیرد، سپس بر روی سطح یکی از لولهها به مقدار2- 1سانتیمتر، پارافین مایع استریل اضافه میگردد تا رشد باکتری در شرایط بیهوازی قرار گیرد، در صورتیکه لوله اولی در شرایط هوازی قرار دارد.
اگر چنانچه لوله کشت در شرایط هوازی زرد رنگ شد و لوله دومی بدون تغییر رنگ باقی ماند، باکتری هوازی بوده و گلوکز را اکسیده نموده است که از جمله خصوصیات سودوموناسها میباشد و اگر لوله فاقد پارافین به رنگ آبی تغییر رنگ داد و لوله دارای پارافین بدون تغییر باقی ماند، نشانه اکسیداسیون پروتئینها بوده که از جمله صفات آلکالیژنز میباشد. اگر هر دو لوله به رنگ زرد تغییر رنگ دادند، نشاندهنده تخمیری بودن باکتری میباشد.
نکته :
انجام آزمایش تخمیر در محیط OF نیاز به چهار روز وقت دارد. به لحاظ سرعت عمل، نبودن امکانات و توجه به میزان کارآئی بالینی، انجام شناسایی کامل NFB در آزمایشگاههای معمولی امکانپذیر نمیباشد، لذا در اینجا سعی شده که روشهای عمل جهت شناسایی نسبی آنها ارائه شود.
سودوموناس
باسیلهای گرم منفی، مستقیم یا كمی خمیده، هوازی مطلق، اكثرا” متحرك توسط فلاژل قطبی منو و مولتیتریش، بدون اسپور، عدهای كپسولدار، اكسیداز و كاتالاز مثبت هستند. متابولیسم آنها تنفسی بوده و هرگز تخمیری نمیباشند، لذا گلوكز و عدهای از قندها را از راه اكسیداتیو مصرف مینمایند. بین 4 تا 43 درجه سلسیوس رشد میکنند. بعضی پیگمانهای مختلف محلول و غیرمحلول در آب تولید میكنند.
سودوموناس آئروژینوزا (p.aeroginosa )
سودوموناس آئروژینوزا باسیل گرم منفی، اكسیداز مثبت و متحرك است كه 0/5 تا 0/8 میكرومتر پهنا و 1/5 تا 3 میكرومتر طول دارد و دارای یك تا سه تاژك میباشد. بجز مواقعی كه در حضور نیترات رشد میكند و آنرا به نیتریت احیا مینماید، در سایر موارد هوازی اجباری میباشد. سودوموناس قادر به تخمیر كربوهیدراتها نیست، اما از لحاظ تغذیه انعطافپذیر است و قادر به متابولیزه بیش از 80 ماده آلی بوده و حتی بر روی سادهترین محیطهای كشت نیز قابلرشد میباشد.
این خصوصیات متابولیكی، نقش سودوموناس را در طبیعت نمایان میسازد. این باكتری در آب و خاك یافت شده و در تجزیه مواد آلی نقش دارد. سودوموناس آئروژینوزا، تست سیمون سیترات و آرژینین دهیدرولاز مثبت، لیزین دكربوكسیلاز و اورنیتین دكربوكسیلاز منفی دارد و در محیط كشت كلیگلرآیرون آگار تولید H2S نمینماید. بدلیل تولید تریمتیلآمین، محیط كشتهای سودوموناس آائروژینوزا مشخصا” بوی میوه میدهند.
بیماری
سودوموناس آئروژینوزا یکی از عوامل اصلی ایجاد کننده عفونتهای بیمارستانی می باشد و در افرادی که دچار ضعف سیستم ایمنی هستند، سبب بیماریهایی مانند عفونت گوش میانی (Swimmers ear)، پوستی (به خصوص افراد دچار سوختگی)، باکتریمی، عفونت مغز استخوان و مفاصل، مننژیت و آبسههای مغزی، کراتیت، انتروکولیت، تب شانگهای (مشابه حصبه)، اندوکاردیت، پنومونی و عفونت مجاری ادراری میگردد.
زیستگاه و نحوه انتقال
سودوموناس آئروژینوزا در خاک، آب، گیاهان و حیوانات وجود دارد. بر روی پوست و دستگاه گوارش حدود 3 درصد از مردم عادی یافت میشود و توسط 20 درصد از پرسنل بیمارستانها حمل میشود. علاقه به پایداری در فضای بیمارستان دارد، زیرا در برابر بسیاری از ضدعفونی کنندهها و آنتیبیوتیكها مقاوم است. انتقال آن بوسیلة پزشكان و پرستاران ( دستها و..) وسایل تنفسی و غیره صورت میگیرد و به همین دلیل از عوامل خطرساز برای بیماران بستری می باشد. این باكتری به علت داشتن مقاومت به بسیاری از داروها و مواد ضدعفونی كننده، در مواد مصرفی ( الكل، بتادین رقیق و …. ) که برای ضدعفونی نمودن بیماران استفاده میشود، رشد نموده و با استفاده از آنها سبب آلودگی و عفونت میگردد. این باکتری در آب مقطر و آب معمولی زنده میماند و تکثیر مییابد. سودوموناس آئروژینوزا، متنوعترین باکتری مطرح در پزشکی از نظر منبع انرژی و کربن است.
تشخیص آزمایشگاهی
خون، مدفوع، ادرار، CSF، خلط، ترشحات گوش میانی و چشم و ضایعات پوستی نمونههای ارسالی به آزمایشگاه می باشند. برای تشخیص سودوموناس آئروژینوزا از روشهای زیر استفاده میشود:
رنگ آمیزی گرم
بصورت باسیلهای گرم منفی مستقیم یا کمی خمیده است و برخلاف آن اسینتوباکتر معمولاً خیلی کوتاه و اغلب کوکوئیدی است و نیز موراکسلا که کوتاه و غالباً جفت جفت یا به شکل زنجیره کوتاه میباشد.
کشت
سودوموناسها بر روی اکثر محیطهای آزمایشگاهی مثل بلادآگار و محیطهای کشت افتراقی که برای رشد انتروباکتریاسه بکار میرود (مانند مکانکی) رشد میکنند. روی محیط SS در حدود 88% موارد رشد دارند. در محیط TSI فرم قلیا /قلیا (ALK/ALK) ایجاد کرده و روی سطح شیبدار آن کلنیهایی با جلای فلزی مشاهده می شود. کشت، آزمایش اختصاصی برای تشخیص عفونتهای سودوموناس آئرژینوزا میباشد.
نکته مهم: کشت این باکتری به علت تولید تریمتیلآمین دارای بوی مخصوص و مطبوع شبیه گل یاس یا انگور، عسل، شكوفه زرد آلو و ذرت مکزیکی میباشد.
انواع کلنی
سودوموناس آئروژینوزا بر روی محیط نوترینت آگار(NA) پس از 24 ساعت در شرایط هوازی در º37 سیلسیوس، شش تیپ 1-6)) كلنی ایجاد میکند که تیپهای1 و 5 دارای اهمیت بیشتری میباشند.
Type I : کلنیبزرگ، كمی محدب، درشت، خشن و تخممرغی، با حاشیه مضرس داشته که بیشتر از بقیه قابل مشاهده است.
Type V : كلنی موكوئید و تولید كنندة آلژینات، برجسته و به رنگهای مختلف میباشد. این کلنیها معمولاً از خلط افراد مبتلا به فیبروزیس سیستیک جدا میشود.
نکته:
کلنیهای تیپیک سودوموناس آئرژینوزا برروی محیط بلادآگار بزرگ (5-3 میلیمتر)، تخت با حاشیه پر مانند و مضرس، سطح صاف و با همولیز بتا میباشد. نمونههایی که از منابع طبیعی بدست میآیند دارای کلنیهای کوچک می باشند.

کلنی سودوموناس آئرژینوزا روی محیط بلاد آگار

کلنی موکوئیدی سودوموناس آئرژینوزا روی محیط مکانکی آگار
پیگمان
بر روی محیطهای بیرنگ مثل مولرهینتون به خوبی مشخص میشود. وجود پیگمان پیوسیانین (آبی رنگ) مختص سودوموناس آئرژینوزا میباشد. البته پیگمانهای دیگر هم ممکن است توسط این باسیل تولید شود که رنگ آبی را پوشانده و رنگ زرد، سبز، قرمز و یا قهوهای ایجاد نماید، لذا اگرچه مشاهده پیگمان پیوسیانین تشخیص سودوموناس آئرژینوزا را تائید میکند، ولی ندیدن آن دلیل بر رد تشخیص نیست.

کلنی سودوموناس آئرژینوزا روی محیط مولرهینتون(به رنگ سبز مایل به آبی توجه شود)
كشت در محیط حركت
كشت باكتریهای غیر تخمیری در فاصله mm 4 در سطح محیط و مشاهده واكنش پس از 6-4 ساعت (تیرگی و كدورت در سطح محیط) صورت میگیرد و با انكوباسیون طولانی واكنش ناپدید می شود. قرار دادن در حرارت 25 درجه سیلسیوس به مدت 48- 24 ساعت سبب كند شدن تقسیم و افزایش مشاهده حركت میشود.
محیط Motility B medium حاوی 2،3، 5 تری فنیل تترازولیوم کلراید(TTC)میباشد که مناسب برای مشاهده حركت است. چون سودوموناسها هوازی بوده، روی محیطهای حرکت در سطح رشد میكنند، لذا نمیتوان روی آن محیط ها حرکت آنها را مشخص کرد، لذا از محیط فوق استفاده میشود که باکتری متحرک تترازولیوم را احیا کرده و حلقه قرمز رنگ را بوجود آورد. همه سودوموناسها متحركند و رشد باكتری بصورت حلقهای در اطراف لوله هم قابل مشاهده میباشد.
نکات مهم:
– وجود پپتون، یونهای منیزیم و سولفات در محیطهای کشت، استفاده از محیطهای حاوی ژلاتین و شیر و همچنین قرار دادن محیط کشت در دمایcº 30-25، سبب افزایش تولید پیگمان میگردند. لازم بذکر است که افزایش یون فسفات سبب افزایش تولید پیگمان فلورسین و کاهش تولید پیوسیانین میگردد.
– برای جدا کردن این باکتریها از مواد آلوده، از ترکیبات چهار ظرفیتی آمونیم و ساولن و یا از محیط حاوی 3صدم % ستریماید (Citrimide) استفاده مینمایند.
– حداقل ابزار تشخیصی برای سودوموناس آئرژینوزا
مشاهده کلنی تیپیک بتاهمولیتیک + تست اکسیداز مثبت.
تشخیص سودوموناس آئرژینوزاهای بدون پیگمان ها
10% از سویههای سودوموناس آئرژینوزاها در جداسازی اولیه پیگمان تولید نمیکنند. در این موارد رشد در 42 درجه سلسیوس و در سابکالچرهای مختلف و عدم رشد در 4 درجه سلسیوس و توانایی احیاء نیترات به گاز نیتروژن میتواند مؤید تشخیص سودوموناس آئرژینوزا باشد.
بررسی خصوصیات بیوشیمیائی
سودوموناس آئرژینوزا دارای قدرت پروتئولیتیکی شدید می باشد و ژلاتین را به سرعت مثبت می کند. اوره آز، اکسیداز، کاتالاز و آرژینین دهیدرولاز مثبت است. لیزین دكربوكسیلاز، لاکتوز و اورنیتین دكربوكسیلاز منفی است. IMViC=–++ و روی KIA و TSI به صورت AIK/AIK است و H2S منفی است. همولیز کامل روی محیط بلاد آگار میدهد.
تست اكسیداز
این گروه از باكتریها اكثراً اكسیداز مثبت می باشند و به راحتی با انجام تست پس از 60-10 ثانیه معرف احیا شده را اكسیده نموده و از بیرنگ به رنگ صورتی تبدیل میكنند. برای انجام این تست بایستی از کلنی هایی استفاده شود که بر روی محیط فاقد مواد رنگی و گلبول قرمز باشند تا از ایجاد نتایج مثبت کاذب جلوگیری شود .
سروتایپینگ
آنتیژن LPS در سودوموناس، مقاوم به حرارت، اختصاصی گروه بوده که بوسیلة تست آگلوتیناسیون بر اساس آنتیژن نوعO سروتیپ میگردد. 90% سوشها دارای این آنتیژن میباشند. بر اساس آنتیژن H، 50% سوشها دارای این آنتیژن میباشند. این آنتیژنها با روشهای ایمونوفلورسنس هم قابل اندازهگیری میباشند.
باكتریوسین تایپینگ
بر اساس تولید پیوسین صورت میگیرد و یك روش معمول و رایج است. حتی از روش سروتیپ كارآیی بیشتری دارد و برای كلنیهای موكوئیدی هم قابل اجرا میباشد.
درمان
بعد از آنتیبیوگرام با تیکارسیلین، پیپراسیلین به همراه یک آمینوگلیکوزید (توبرامایسین)، آزترئونام، ایمیپنم و کینولونها (سیپروفلوکساسین)، سفتازیدیم و سفوپرازون.
آنتیبیوگرام
نظر به اینکه این باکتریها نسبت به اکثر آنتیبیوتیکها مقاوم میباشند، بهتر است آنتیبیوگرام برای آن صورت بگیرد. همچنین بررسی الگوی مقاومت دارویی میتواند در تأیید تشخیص مؤثر باشد. سودوموناس آئرژینوزا بجز آمینوگلیکوزیدها و کلستین و پلی میکسین B به بیشتر داروها مقاومت دارد. البته برخی از انواع این باسیل که از خط افراد مبتلا به فیبروزیس سیستیک جدا میشوند، حساسیت بیشتری داشته و به آمپیسیلین و نالیدیکسیک اسید حساس هستند.
بورخولدریا (سودوموناس) سودومالئی
بورخولدریا (سودوموناس) سودومالئی یا باسیل ویت ـ موریس یك باكتری آزادزی است كه در آبهای گرم و خاك مرطوب جنوب شرقی آسیا یافت میشود. این باكتری در مزارع برنج عامل بیماری بنام ملیوئیدوزیس یا بیماری بمب ویتنام است. عفونت انسانی با بورخولدریا سودومالئی معمولاً با ورود باكتری از طریق زخمها، بریدگیها یا خراشها آغاز میشود. به هرحال در بعضی از موارد، آلودگی از طریق تنفس باكتری توسط فرد سالم؛ یا در افراد بستری در بیمارستان از طریق وسایل برونكوسكوپی و كاتتر ادراری آلوده و یا كاركنان آزمایشگاه در حین كشت بورخولدریا سودومالئی آغاز میشود.
بورخولدریا سودومالئی در گروه rRNA II سودوموناسیه (گروه سودومالئی) قرار دارد. در بیشتر محیطهای كشت استاندارد میكروبیولوژی ایجاد كلنیهای فشرده (Wrinkled colonies)میکند. بورخولدریا سودومالئی رنگ را بصورت دو قطبی به خود گرفته و در زیر میكروسكوپ به شكل سنجاق قفلی (Safety pin) دیده میشود. باكتری اكسیداز مثبت است و نیترات را به نیتریت احیا مینماید. لیزین دکربوکسیلازمثبت و Dnase منفی و به پلیمیکسین مقاوم میباشند. درمحیط تریپل شوگرآیرون آگار (TSI) بعد از 24 ساعت بصورت ایجاد اسید در سطح و خنثی در ته لوله در میآید ولی بعد از 72 ساعت ته لوله نیز بصورت اسیدی در میآید. آنتیسرمها نیز در تشخیص سویههای بورخولدریا سودومالئی استفاده میشوند.
اسینتوباکتر
باکتریهای هوازی گرم منفی هستند که به طور وسیعی در خاک و آب وجود دارند و گاهی از پوست، غشاهای مخاطی، ترشحات و محیط بیمارستان جدا میشوند.اسینتوباکتر بومانی (A. baumannii) شایعترین گونه جدا شده است. گونههای دیگر نظیر اسینتوباکتر لوفی (A. lwoffii)، اسینتوباکتر جانسونی (A.johnsonii)، اسینتوباکتر همولیتیکوس (A. heamolyticus) و سایر گونهها بندرت جدا میشوند. قبلاً اسینتوباکترها با نامهای مختلفی نظیر میما پلی مورفا (Mima polymorpha) و هرلا واژینیکولا (Herellea vaginicolla) که بیانگر خصوصیات ارگانیسمها بود، نامیده میشدند.
اسینتوباکتر بومانی که برخلاف سایر گونههای شایع در دمای 44 درجه سلسیوس نیز رشد دارد از خون، خلط، پوست، مایع جنب و ادرار (معمولاً در عفونتهای همراه با تجهیزات پزشکی) جدا میشود. اسینتوباکتر جانسونی پاتوژن بیمارستانی با بیماریزایی محدود بوده و در کشت خون بیماران دارای کاتترهای پلاستیکی داخل وریدی دیده میشود. اسینتوباکترهایی که از پنومونیهای بیمارستانی جدا میشوند، اغلب از مرطوبکنندها یا خنک کنندهها منشأ گرفتهاند. این باکتریها در بین NFB بعد از سودوموناس بیشترین وفور را در نمونه های کلینیکی دارند.
تشخیص آزمایشگاهی
از نمونههای خون، مایع پلور، ادرار، ضایعات پوستی میتوان این باکتریها را جدا کرد.
رنگ آمیزی گرم: کوکوباسیل یا باسیل های کوتاه میباشند که در روی محیطهای جامد و نمونههای کلینیکی اغلب به شکل دیپلوکوک میباشند و با نایسرها اشتباه میشوند. این باکتریها، گرم منفی میباشند که گاهی اوقات گرم مثبت مشاهده میشوند (گرم متغیر).
رنگآمیزی گرم گونههای اسینتوباکتر
کشت:
برروی بیشتر محیطهای معمولی رشد میکند. روی بلادآگار ایجاد کلنیهای محدب، خاکستری تا سفید به قطر 3-2 میلیمتر با همولیز متغیر ایجاد میکند. کلنی آن در روی مکانکی شبیه سایر لاکتوز منفیها میباشد. در عمق TSI نمیتواند رشد نماید و الگوی TSI آن مانند سودوموناس ALK/ALK میباشد. در جدول زیر مشخصات مهم اسینتوباکتر بومانی و لوفی نشان داده شده است.
عدم تخمیر گلوکز وجه افتراق آن با انتروباکتریاسه و تست اکسیداز وجه تمایز آن با نایسر میباشد (اسینتوباکتر برخلاف نایسرها اکسیداز منفی میباشد) .
کلید تشخیصی اسینتوباکتر:
درمان
سویههای اسینتوباکتر اغلب نسبت به عوامل ضدمیکروبی مقاوم بوده و درمان عفونتهای حاصل از اینها مشکل است. برای انتخاب بهترین درمان ضدمیکروبی انجام تست تعیین حساسیت ضروری است. این باکتریها به سولفونامیدها، سفالوسپورینهای قدیمی، اریترومایسین، تتراسایکلین و کلرامفنیکل مقاوم بوده و اکثر موارد، سویههای اسینتوباکتر نسبت به جنتامایسین، آمیکاسین، توبرامایسین و پنیسیلینها یا سفالوسپورینهای جدید و آمینوگلیکوزیدها پاسخ میدهند.
استنوترفوموناس
این باکتریها در بین NFB بعد از سودوموناس و اسینتوباکترT بیشترین وفور را در نمونههای کلینیکی دارند.استنوتروفوموناس مالتوفیلیا (گزانتوموناس) مهمترین گونه این جنس میباشد. آن در مواد ضدعفونی کننده و آب وجود دارد و عامل عفونت بیمارستانی (بهخصوص در بیماران بستری در ICU)، پنومونی، باكتریمی اولیه، سپسیس و عفونت ادراری میشود. این باکتری به خوبی روی محیطهای بلاد اگار و مکانکی آگار رشد میکند. اکسیداز منفی و تست OF گلوکز آن منفی، ولی تست OF مالتوز آن مثبت میباشد. لیزین دکربوکسیلاز، اسکولین، DNase مثبت و بعضی از گونههای آن پیگمانت تولید میکنند. آنها به پلیمیکسین حساس میباشند.
آلکالیژنز
گروه آلکالیژنها که شامل چهار گونه باسیل گرم منفی میباشند، ممکن است قسمتی از فلور طبیعی انسان باشند و از دستگاههای تنفس مصنوعی، اسپریها و دستگاه دیالیز جدا شوند. آنها گاهی از ادرار، خون، مایع نخاعی، زخمها و آبسهها بدست میآیند. آنها اکسیداز و کاتالاز مثبت بوده و دارای تاژکهای پریتریش (وجه تمایز از سودوموناسها) میباشند. این باکتریها محیط نیترات و محیط OF را که دارای گلوکز است را قلیایی مینمایند و اورهآز و نیترات منفی میباشند. برروی بلادآگار کلنیهای سفید، صاف، بزرگ و خشن با حاشیه نامنظم ایجاد میکنند و همچنین قادر به رشد در روی مکانکی میباشد. شکل و اندازه کلنی آن روی مکانکی متغیر میباشد، اغلب به باکتریم حساس میباشند.

کلنی آلکالیژنز فکالیس روی محیطهای بلاد آگار
موراکسلا
موراکسلا کاتارالیس و سایر موراکسلاها جزء فلور طبیعی دستگاه تنفسی فوقانی هستند و گاهی باکتریمی، اندوکاردیت، کونژنکتیویت، مننژیت برونشیت، پنومونی، سینوزیت و عفونت گوش میانی بوجود میآورند.
کوکوباسیلهای گرم منفی، اکسیداز و کاتالاز مثبت، غیرمتحرک و بدون پیگمان که کربوهیدراتها را مصرف و تخمیر نمیکنند، بیشتر گونههای آن به آهستگی بر روی مکانکی رشد میکنند، ولی M.lacunata وM. catarrhalis که از چشم جدا میشود رشد نمیکند، اما روی بلادآگار بدون تولید همولیز ایجاد حفره مینماید. از سایر NFB براساس واکنش در محیط OF، تست اکسیداز و تحرک قابل افتراق است. نسبت به پنیسیلین حساس است که این میتواند وجه افتراق آن از اسینتوباکتر باشد.
موراکسلا کاتارالیس که قبلاً به آن برانهاملا کاتارالیس میگفتند از نظر شکلی مشابه نایسریاها میباشد و قدرت رشد روی تایر مارتین و بلادآگار را دارد. درتست CTA هیچ قندی را مصرف نمیكند و حتی ممكن است باعث قلیاییتر شدن محیط گردد و براساس قدرت احیاء نیترات، عدم قدرت تخمیر و دارا بودن قدرت تولید DNase و تولید بوتیرات استراز از سایر نایسریاها افتراق داده میشود. اغلب آنها نسبت به پنیسیلین و سایر داروهای ضدمیکروبی حساسند. موراکسلا کاتارالیس اغلب بتالاکتاماز تولید میکند.
ایکنلا
ایکنلا کورودنس (Eikenella corrodens) یک باسیل گرم منفی، کاپنوفیلیک سختگیر و کوچک میباشد که قسمتی از فلور لثه و روده را در 40 تا 70% انسانها تشکیل میدهد. این باکتری در زخمهای ناشی از گاز گرفتن توسط انسان به همراه استرپتوکوکها مشاهده میشود و در مننژیت، اندوکاردیت، پنومونی ناشی از آسپیراسیون و غیره جدا میگردد.
این باکتری برای رشد به خون و رطوبت نیاز دارد و روی محیطهای مککانکی و EMB رشد نمیکند، اما وجود CO2 رشد آن را تسریع کرده و برخی سوشهای آن در ابتدا تنها در شرایط بیهوازی قابل جداسازی هستند. کلنیهای این باکتری بسیار ریز بوده و بوی آب ژاول (هیپوکلریت سدیم) میدهند؛ همچنین در حدود 50% موارد با تولید آنزیم آگاراز طی چند روز در محیط کشت حفره ایجاد میکنند و در نهایت به دلیل مقاومت به کلیندامایسین، میتوان از این آنتیبیوتیک برای تهیه محیط کشت انتخابی آن بهره برد.
این باکتری اکسیداز، اورنیتین دکربوکسیلاز و نیترات مثبت، کاتالاز، اورهآز، اندول هیدرولیز اسکولین، ONPG و تخمیر کربوهیدرات ها منفی میباشد. هیدرولیز اسکولین و ONPG منفی میباشد. در محیط آبگوشت حاوی گلوکز بصورت گرانولهای مجزا رشد کرده و اغلب به دیواره لوله میچسبد (جدول 1).
جدول(1): تمایز باکتریهای غیرتخمیری مهم از نظر کلینیکی
|
باکتری |
اکسیداز |
رنگ آمیزی گرم |
رشد روی مکانکی |
حرکت |
|
سودوموناس آئرژینوزا |
+ |
باسیل |
+ |
+ |
|
سایر گونههای سودوموناس |
+ |
باسیل |
+ |
+ |
|
اسینتوباکتر |
– |
کوکوباسیل |
+ |
– |
| موراکسلا
|
+ |
کوکوباسیل |
(+) |
– |
|
آلکالیژنز |
+ |
باسیل |
+ |
+ |
|
ایکنلا |
+ |
باسیل |
– |
? |

سلام وقت بخیر.این مطالب منبعش کجا بوده؟خیلی عالی و کامل بود.اگر کتاب بوده میشه معرفی کنید؟